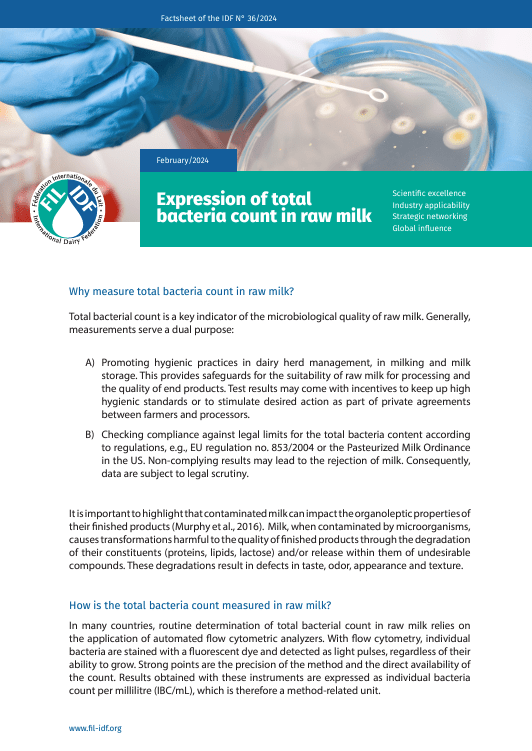
Factsheet of the IDF N° 36/2024: Expression of total bacteria count in raw milk - FIL-IDF

Factsheet of the IDF N° 36/2024: Expression of total bacteria count in raw milk
Regular price
FREE
Regular price
Sale price
€0,00
Unit price
per
Couldn't load pickup availability
Document info
| pages | 4 |
|---|---|
| published date | 29 February 2024 |
| reference | Factsheet of the IDF N° 36/2024 |
Publication description
Understanding the total bacterial count in raw milk is crucial for assessing its microbiological quality. This factsheet explains the measurement processes and the different expressions of results.
For more detailed information, please read the Bulletin of the IDF N° 511/2021.
Cite this content as:
International Dairy Federation. (2024). Expression of total bacteria count in raw milk (Factsheet of the IDF N° 36/2024). https://doi.org/10.56169/OKRO5237